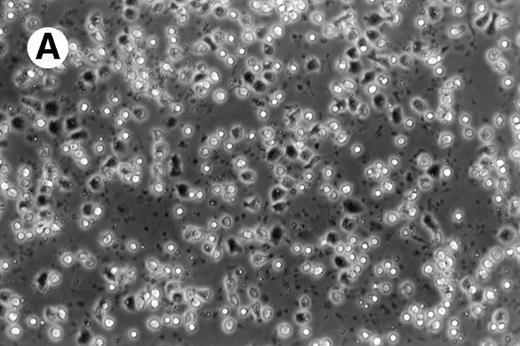

Abstract
We have previously reported that leukemic dendritic cells (DC) can be generated ex vivo from myelomonocytic precursors in chronic myelogenous leukemia. In this study we report the generation of DC from acute myelogenous leukemia (AML) cells and their potent ability to stimulate leukemia-specific cytolytic activity in autologous lymphocytes. DC were generated in vitro using granulocyte-macrophage colony-stimulating factor +interleukin-4 in combination with either tumor necrosis factor- or CD40 ligand (CD40L). Cells from 19 AML patients with a variety of chromosomal abnormalities were studied for their ability to generate DC. In all but 1 case, cells with the morphology, phenotypic characteristics, and T-cell stimulatory properties of DC could be generated. These cells expressed high levels of major histocompatibility complex class I and class II antigens as well as the costimulatory molecules B7-2 and ICAM-1. In three cases these cells were determined to be of leukemic origin by fluorescence in situ hybridization for chromosomal abnormalities or Western blotting for the inv(16) fusion gene product. Autologous lymphocytes cocultured with AML-derived DC (DC-AL) were able to lyse autologous leukemia targets, whereas little cytotoxicity was noted against autologous, normal cells obtained from the patients during remission. We conclude that leukemia derived DC may be useful for immunotherapy of many AML patients.
ACUTE MYELOGENOUS leukemia (AML) encompasses a group of disorders characterized by clonal accumulation of myeloid blasts in the blood and marrow. The malignant cells exhibit variable degrees of myeloid differentiation and are associated with a number of well-characterized cytogenetic abnormalities and gene rearrangements. Specific cytogenetic changes are often associated with specific disease phenotypes and clinical outcomes.1 Normal pluripotent hematopoietic stem cells coexist in the marrow with the leukemic clone. After successful antileukemic therapy, the normal hematopoietic elements repopulate the marrow. In most cases, the remission is only transient. The therapeutic challenge for most patients with these disorders thus lies in achieving long-term remission.
There is considerable data indicating immune activity against human leukemias. The therapeutic efficacy of allogeneic marrow or stem cell transplant is at least in part due to the graft versus leukemia effect.2 Autologous immune responses have also been suggested. Interleukin-2 (IL-2) infusion has been used for AML both at the time of relapse3 and in remission.4
Dendritic cells derived from the myeloid lineage have been characterized as the primary professional antigen-presenting cells (APC) responsible for eliciting T-cell responses.5,6Considerable interest has developed in the potential use of dendritic cells (DC) for the generation of effective cancer immunotherapy. We recently reported that human chronic myelogenous leukemia (CML) will differentiate into DC under the influence of the cytokines granulocyte-macrophage colony-stimulating factor (GM-CSF), IL-4, and tumor necrosis factor-α (TNF-α) and that these DC elicit leukemia-specific cytotoxicity in autologous lymphocytes.7We speculated that this approach to the development of antileukemic immunoreactivity might be extended to other diseases. Santiago-Schwartz et al8 showed in one case that AML cells were able to give rise to cells of dendritic phenotype and function in culture.
We present here results of AML cultured for the ex vivo development of DC and the cytotoxic activity of autologous lymphocytes stimulated by the AML-derived DC.
MATERIALS AND METHODS
Patient samples.
Blood and bone marrow samples for this study were collected from patients with informed consent at the time of sample collection for diagnostic tests under guidelines and procedures approved by the institutional review board of the M.D. Anderson Cancer Center. Relevant clinical and diagnostic laboratory data for the 19 cases are shown in Table 1. Remission samples were collected during morphological remission (<5% marrow blasts) after therapy for the disease. Patients 1 and 11 were the only ones with any history of antecedant hematological disorder.
Generation of DC from AML cells.
Recombinant human IL-4 was kindly provided by Schering-Plough, Kenilworth, NJ. Recombinant human TNF-α was kindly provided by The National Institutes of Health, Bethesda, MD. Recombinant trimeric human CD40L was kindly provided by Immunex Corp, Seattle, WA. This is a trimeric, soluble molecule capable of binding to and activating the CD40 receptor. Peripheral blood mononuclear cells (PBMNC)were separated from AML patients and normal donors using a Histopaque-1077 density gradient (Sigma, St Louis, MO) and cultured immediately or cryopreserved. To generate DC, mononuclear cells at 2 to 4 × 106 cells/mL were cultured in 75-mm2 tissue culture flasks (Corning Inc, Corning, NY) in Aim-V serum-free medium (GIBCO Laboratories, Grand Island, NY) with various combinations of human cytokines. Recombinant GM-CSF (Immunex) and IL-4 were added at a final concentration of 1,000 U/mL. Recombinant TNF-α was used at a final concentration of 500 U/mL. Recombinant CD40L was added at a concentration of 1 μg/mL. The medium was changed every 3 to 4 days, and the unfractionated AML cell cultures were used for phenotypic and functional studies.
Phenotypic analysis of cells by flow cytometry.
Fluorescein- or phycoerythrin-conjugated mouse monoclonal antibodies against CD3, CD14, CD19, as well as fluorochrome-labeled isotype controls were purchased commercially (Becton Dickinson, Duarte, CA). Fluorescein- or phycoerythrin-labeled antibodies against HLA-D, HLA-A, HLA-B, HLA-C, CD1a, CD40, CD54, CD80, and CD86 were purchased from Pharmingen (San Diego, CA). Freshly isolated or day-14 cells were dispersed to single-cell suspension by gentle trituration through a pitpette. They were then incubated with various combinations of antibodies, washed with phosphate-buffered saline (PBS)-hIgG and analyzed using a FACSscan II flow cytometer and the LYSIS software (Becton Dickinson). Forward scatter versus side scatter gates were set up during analysis to eliminate debris and clumps, and the remaining cell populations were analyzed for expression of phenotypic markers.
Genetic analysis of cells by fluorescence in situ hybridization (FISH).
To determine if the DC generated in culture were derived from the leukemic clone or the normal population of the patients’ peripheral blood cells, we selected 2 patients whose leukemic cells were known to exhibit a specific chromosomal abnormility, ie, trisomy of chromosome 8, that could be easily identified in the interphase nuclei by FISH. Freshly isolated PBMNC, as well as dendritic cells generated in the culture following 14 days of incubation with GM-CSF, IL-4, and TNF-α or CD40 ligand were analyzed. Fluorescein-labeled chromosome 8–specific alpha satellite DNA probe (Oncor, Gaithesburg, MD) was used according to the manufacturer’s instructions. At least 400 interphase nucleii were examined in each sample to quantitate the percentage of cells with three hybridization signals for chromosome 8.
Western blotting for CBFB-MYH11.
Allogeneic mixed leukocyte response.
PBMNC from normal volunteers were used as responder cells. Freshly isolated or 10- to 14-day cultured AML cells irradiated with 30 Gy were used as stimulator cells. A total of 2 × 105allogeneic PBMNC were added as responders to varying numbers of accessory cells. Lymphocyte proliferation was measured after 5 days of culture with addition of 3H-thymidine for 18 hours.
Expansion of T cells from AML patients and stimulation with autologous DC.
PBMNC of AML patients were suspended at a concentration of 5 × 106 cells/mL and cultured in Aim-V containing 1 μg/mL anti-CD3 antibody (Ortho Biotech, Raritan, NJ) and 100 U/mL of IL-2. Nonadherent cells were resuspended in fresh medium containing 100 U/mL IL-2 every 3 days. On day 7 the cells were washed and cocultured at a ratio of 3:1 with washed autologous AML-DC or freshly thawed washed autologous leukemia cells in Aim-V Medium without additives for 3 days. The dendritic cell activated lymphocytes (DC-AL) or fresh leukemia-stimulated lymphocytes were expanded for an additional 4 to 7 days in IL-2 containing medium before being assayed for antileukemic activity.
T-cell cytotoxicity assay.
T-cell cytotoxicity was measured in vitro using the lactate dehydrogenase-release assay.10 Cryopreserved, thawed target cells were cocultured with T cells at effector target ratios of 1:1, 1:10, and 1:25 ratios for 6 hours in 96-well round-bottomed plates in phenol red-free RPMI + 0.1% human albumin (Miles Inc, Elkhart, IN). Spontaneous release of effector and target cells was controlled by separate incubation of the respective populations. Maximal LDH enzyme release was measured after lysis of the target cells with 0.5% triton X-100 (Sigma). Cell-free supernatants were incubated in a separate 96-well plate with lactate dehydrogenase (LDH) substrate10 for 10 minutes before measuring absorbance using a microplate reader (Dynatech MR5000) at 490 nm with a 650-nm reference. Percentage cytotoxicity was calculated according to the formula:
whereE is the LDH release by effector-target coculture, Stis the spontaneous release by target cells, Se is the spontaneous release by effector cells, and M is the maximal release by target cells.
RESULTS
Characteristics of AML PBMNC cultured in various cytokine combinations.
PBMNC from AML patients of a variety of FAB types, clinical histories, and cytogenetics were used to generate DC. Clinical details of the AML patients whose cells were used are listed in Table 1. As may be seen, patients had a variety of FAB types and cytogenetic changes. Two patients (patients 1 and 11) had histories of antecedant hematological disorders (anemia or myelodysplastic syndromes) before AML diagnosis. Nearly all cultures for this work were initiated from samples cryopreserved at a previous date. Because of the limited material available from any given patient, not all studies shown could be done for every patient’s leukemia.
Cultures of AML cells were replenished with fresh medium and cytokines every 3 to 4 days. Cells cultured in various cytokine combinations were assessed for total number of viable cells and cells with dendritic morphology after various culture periods. Approximately 25% to 45% of the initial cell population was recovered after 9 days of culture. No significant change in numbers of cells was observed between day 9 and day 20 of culture (not shown). Similar yields of viable cells were noted for AML cell cultures from other patients. Freshly isolated AML PBMNC displayed a spherical morphology without discernable cells exhibiting dendritic processes (Fig 1A). Between days 10 and 14, cultures with GM-CSF, IL-4, and TNF-α (Fig1B) or GM-CSF, IL-4, and CD40L (Fig 1C) consistently displayed an increase in cell size and showed cell clusters with dendritic morphology in all but one AML patient (patient 16).
Morphology of freshly isolated and cultured AML cells. Phase contrast micrographs of freshly isolated AML PBMNC (A; 100× origonal magnification); AML cells cultured for 14 days in GM-CSF, IL-4, and TNF (B; 250× original magnification); or GM-CSF, IL-4, and CD40L (C; 250× origianl magnification). (A and B) Obtained with cells from patient 13; (C) Obtained with cells from patient 18.
Morphology of freshly isolated and cultured AML cells. Phase contrast micrographs of freshly isolated AML PBMNC (A; 100× origonal magnification); AML cells cultured for 14 days in GM-CSF, IL-4, and TNF (B; 250× original magnification); or GM-CSF, IL-4, and CD40L (C; 250× origianl magnification). (A and B) Obtained with cells from patient 13; (C) Obtained with cells from patient 18.
Phenotype of cultured AML cells.
Flow cytometry has been performed on various cases of AML cultured for 11 to 14 days in GM-CSF, IL-4, and TNF-α or GM-CSF, IL-4, and CD40L. In each of these cases the flow cytometric phenotype of the cytokine-cultured cells has been compared with autologous leukemia, either freshly thawed cells or cells cultured for equivalent periods in medium without cytokines. Figure 2 shows the phenotype of AML cells of one representative patient (patient 18), cultured in medium alone (Fig 2A); GM-CSF, IL-4, and TNFα (Fig 2B); or GM-CSF, IL-4, and CD40L (Fig 2C). Consistent with the increase in cells of dendritic morphology, the triple cytokine cultures showed an upregulation of the dendritic cell lineage marker CD1a as well as the costimulatory molecules B7-1 (CD80), B7-2 (CD86), CD40, and ICAM-1 (CD54). Cells from patients 7 and 10 through 13 were also cultured and analyzed by flow cytometry. In all of these other five cases examined, culture with either cytokine combination generated increases in expression of CD1a, CD80, CD86, and ICAM-1. The cultured cells were negative for CD3 and CD19 (data not shown). Morphological and phenotypic changes of cultured AML cells similar to those described in the current study were also noted with other AML patients in a previous report from our laboratory.11
AML cells cultured in the triple cytokine combinations upregulate expression of costimulatory molecules. PBMNC from AML patients were cultured in the triple cytokine cocktail for 14 days. Cells were labeled with fluorescent monoclonal antibodies and analyzed by flow cytometry. (A) Results obtained with the cells of patient 18 cultured for 14 days in Aim-V alone. (B) Cells cultured in GM-CSF, IL-4, and TNF-. (C) Cells cultured in GM-CSF, IL-4, and CD40L. Cells from patients 7 and 10 through 13 were also studied in similar experiments and comparable increases in CD1a and costimulatory molecule expression were observed.
AML cells cultured in the triple cytokine combinations upregulate expression of costimulatory molecules. PBMNC from AML patients were cultured in the triple cytokine cocktail for 14 days. Cells were labeled with fluorescent monoclonal antibodies and analyzed by flow cytometry. (A) Results obtained with the cells of patient 18 cultured for 14 days in Aim-V alone. (B) Cells cultured in GM-CSF, IL-4, and TNF-. (C) Cells cultured in GM-CSF, IL-4, and CD40L. Cells from patients 7 and 10 through 13 were also studied in similar experiments and comparable increases in CD1a and costimulatory molecule expression were observed.
Demonstration of leukemic origin of cultured DC.
To confirm that the DC arising in culture are in fact derived from the leukemic cells we selected cases with identifiable clonal markers. Cells from patient 7, with trisomy 8, were cultured in the triple cytokine cocktails and analyzed by interphase FISH for +8 genotype. The results obtained with cells cultured in GM-CSF + IL-4 + TNF-α are shown in Fig 3. Freshly isolated PBMNC from patient 7 displayed trisomy 8 in 93% of the cells. After 14 days of culture in GM-CSF + IL-4 + TNF-α, 92% of the cells showed trisomy 8. Eighty-eight percent of the cells cultured in GM-CSF + IL-4 + CD40L were positive for +8. Given that 44% to 87% of the cells in these cultures expressed the morphology and immunophenotype of DC in these cultures (data not shown), the leukemic clones would have to include the dendritic cells in these cultures. Cells from patient 19 cultured in a similar manner with GM + IL-4 + TNF-α showed trisomy 8 in 88% of the cells.
DC-rich AML cell cultures from a trisomy 8 patient show +8 chromosome in their nuclei. Fluorescein-labeled chromosome 8–specific alpha satellite DNA probe was used to perform FISH analysis on freshly isolated PBMNC or cells cultured for 14 days in GM-CSF + IL-4 + TNF-, or GM-CSF + IL-4 + CD40L. Results depicted were obtained with cells cultured in GM-CSF + IL-4 + TNF-. At least 400 interphase nuclei were examined in each sample to quantitate the percentage of cells with three hybridization signals for chromosome 8. Cells from patient 7 and patient 14 were used for this study. The number of +8 positive cells in the three groups of cells were 93%, 92%, and 88%, respectively. With patient 14, only DC generated with GM-CSF + IL-4 + TNF- were analyzed. Eighty-eight percent of the cells were observed to express trisomy 8.
DC-rich AML cell cultures from a trisomy 8 patient show +8 chromosome in their nuclei. Fluorescein-labeled chromosome 8–specific alpha satellite DNA probe was used to perform FISH analysis on freshly isolated PBMNC or cells cultured for 14 days in GM-CSF + IL-4 + TNF-, or GM-CSF + IL-4 + CD40L. Results depicted were obtained with cells cultured in GM-CSF + IL-4 + TNF-. At least 400 interphase nuclei were examined in each sample to quantitate the percentage of cells with three hybridization signals for chromosome 8. Cells from patient 7 and patient 14 were used for this study. The number of +8 positive cells in the three groups of cells were 93%, 92%, and 88%, respectively. With patient 14, only DC generated with GM-CSF + IL-4 + TNF- were analyzed. Eighty-eight percent of the cells were observed to express trisomy 8.
Patient 13, whose leukemic karyotype showed inv(16), yielded cells that on culture were 63% DC. These cells were submitted for Western blotting using antisera directed at the two constituent moieties of the CBFB-MYH11 fusion protein. Results are shown in Fig 4. Signals for both CBFB and MYH11 corresponding to the 70-kD signal expected for the type A variant of this protein12 were seen in both the cultured DC and the thawed native leukemic cells. These bands are similar in intensity, indicating that the cultured cell population continued to express the leukemia associated protein.
AML cells cultured in GM-CSF, IL-4, and TNF- express the inv(16) gene product. AML cells from patient 14 were cultured for 14 days in GM-CSF + IL-4 + TNF-. Triton X-100 lysates of freshly isolated and cultured AML cells were separated by sodium dodecyl sulfate-polyacrylamide gel electrophoresis (SDS-PAGE) and then analyzed by Western blotting using antibodies against the N-termini (C2) and C-termini (AH107) of the CBFB-MYH11 inv(16) gene product. Lysates from K562 cell line served as a negative control.
AML cells cultured in GM-CSF, IL-4, and TNF- express the inv(16) gene product. AML cells from patient 14 were cultured for 14 days in GM-CSF + IL-4 + TNF-. Triton X-100 lysates of freshly isolated and cultured AML cells were separated by sodium dodecyl sulfate-polyacrylamide gel electrophoresis (SDS-PAGE) and then analyzed by Western blotting using antibodies against the N-termini (C2) and C-termini (AH107) of the CBFB-MYH11 inv(16) gene product. Lysates from K562 cell line served as a negative control.
Allostimulatory activity of the cultured DC.
Freshly isolated and cultured AML cells were examined for their ability to stimulate allogeneic T cells in a mixed leukocyte response (MLR) assay. Figure 5 compares the allostimulatory ability of fresh TNF-α combination and CD40L combination cultured PBMNC from five AML patients. In each case GM-CSF + IL-4 together with TNF-α or CD40L showed a higher allostimulatory potential than freshly isolated AML cells.
GM-CSF, IL-4 with TNF- or CD40L are the most effective combinations for augmenting allostimulatory activy of AML cells. Allogeneic MLR assays were performed as described in Materials and Methods. Freshly isolated (▪), GM + IL-4 + TNF-–cultured (▧), and GM + IL-4 + CD40L–cultured (▨) AML cells from five patients were compared for their ability to stimulate PBMNC of a normal allogeneic donor. Results represent the mean ± SD of triplicate cultures.
GM-CSF, IL-4 with TNF- or CD40L are the most effective combinations for augmenting allostimulatory activy of AML cells. Allogeneic MLR assays were performed as described in Materials and Methods. Freshly isolated (▪), GM + IL-4 + TNF-–cultured (▧), and GM + IL-4 + CD40L–cultured (▨) AML cells from five patients were compared for their ability to stimulate PBMNC of a normal allogeneic donor. Results represent the mean ± SD of triplicate cultures.
Stimulation of autologous antileukemic activity by AML derived DC.
Autologous T cells were cocultured with freshly isolated or cultured DC-rich AML cells and tested for cytotoxicity against autologous leukemic or autologous PBMNC obtained in remission. Figure 6 represents the autologous antileukemic cytotoxicity of T cells stimulated with AML-DC, fresh AML cells, or IL-2 alone. In each of these patients, stimulation of autologous lymphocytes with AML-DC markedly increased their cytotoxicity against autologous leukemia targets. Fresh AML cells could induce a minor level of cytotoxicity in 1 of 4 patients. IL-2–expanded lymphocytes failed to show antileukemic cytotoxicity at the target:effector ratio tested. Figure 7A through C represents the cytotoxicity of DC-AL against autologous leukemic and remission cells. In Fig 7A, GM-CSF + IL-4 + TNF-α was used to generate the DC from five additional patients, whereas GM-CSF + IL-4 + CD40L was used to generate DC in Fig 7B. Figure7C represents the reactivity of DC-AL used in Fig 7B, against autologous remission cells. Results depicted in Fig 7B and C comprise a single experiment with the same patient samples, whereas those depicted in Fig 7A represent a different experiment.
Stimulation of autologous, antileukemic cytotoxicity by fresh AML cells, AML-DC cultures, and IL-2 alone. Autologous T cells were cocultured with fresh AML PBMNC, AML-DC–rich cultures, or IL-2 alone as described in Materials and Methods. They were then tested for cytotoxicity against autologous leukemia targets by LDH-release assay. Results represent the mean cytotoxicity of triplicate cultures. (▪) AML-DC–stimulated T cells, (•) fresh AML PBMNC stimulated T cells, (○) T cells cultured in IL-2 alone. Cytotoxicity of DC-AL compared with IL-2–stimulated T cells at 25:1 ratio is significant (P< .005, Student’s t-test) for each patient. Cytotoxicity of fresh AML cell-stimulated T cells compared with IL-2–stimulated T cells at 25:1 ratio is significant (P < .010, Student’st-test) for patient 13.
Stimulation of autologous, antileukemic cytotoxicity by fresh AML cells, AML-DC cultures, and IL-2 alone. Autologous T cells were cocultured with fresh AML PBMNC, AML-DC–rich cultures, or IL-2 alone as described in Materials and Methods. They were then tested for cytotoxicity against autologous leukemia targets by LDH-release assay. Results represent the mean cytotoxicity of triplicate cultures. (▪) AML-DC–stimulated T cells, (•) fresh AML PBMNC stimulated T cells, (○) T cells cultured in IL-2 alone. Cytotoxicity of DC-AL compared with IL-2–stimulated T cells at 25:1 ratio is significant (P< .005, Student’s t-test) for each patient. Cytotoxicity of fresh AML cell-stimulated T cells compared with IL-2–stimulated T cells at 25:1 ratio is significant (P < .010, Student’st-test) for patient 13.
Autologous AML-DC–stimulated T cells lyse leukemic targets but not autologous remission PBMNC. Autologous T cells were cultured with AML-DC cultures and tested as cytotoxic effector cells in an LDH-release assay. Results represent the mean cytotoxicity of triplicate cultures. (A) The antileukemic cytotoxicity of autologous lymphocytes stimulated with DC generated with GM + IL-4 + TNF-; (B) DC generated with CD40L. The effector cells described in (B) were tested for cytotoxicity against remission PBMNC, rather than leukemic cells in (C). (B and C) represent a single experiment, whereas (A) was a separate experiment with a different series of patients. Each symbol represents one patient. Results represent the mean cytotoxicity of triplicate cultures. Cytotoxicity of DC-AL at a ratio of 25:1 against leukemic targets (B) compared with remission targets (C) is significant (P < .005, Student’s t-test) for every patient.
Autologous AML-DC–stimulated T cells lyse leukemic targets but not autologous remission PBMNC. Autologous T cells were cultured with AML-DC cultures and tested as cytotoxic effector cells in an LDH-release assay. Results represent the mean cytotoxicity of triplicate cultures. (A) The antileukemic cytotoxicity of autologous lymphocytes stimulated with DC generated with GM + IL-4 + TNF-; (B) DC generated with CD40L. The effector cells described in (B) were tested for cytotoxicity against remission PBMNC, rather than leukemic cells in (C). (B and C) represent a single experiment, whereas (A) was a separate experiment with a different series of patients. Each symbol represents one patient. Results represent the mean cytotoxicity of triplicate cultures. Cytotoxicity of DC-AL at a ratio of 25:1 against leukemic targets (B) compared with remission targets (C) is significant (P < .005, Student’s t-test) for every patient.
DISCUSSION
These findings show that cells of DC phenoytpe and function can be derived from the majority of human AML samples. Given the known biological heterogeneity of AML, it not surprising that the results are variable and that occasional AML cell samples would fail to show differentiation toward DC. The leukemias show highly variable degrees of maturation arrest in vivo and highly variable degrees of monocytoid differentiation. The ontogeny of DC is thought to proceed directly through CD34 progenitors or through the monocyte lineage, and in fact cells of dendritic cell phenotype may be derived from normal monocytes.6 The ability of a given leukemia to differentiate toward DC may be tied to the level of maturation block in the monocytoid lineage.
Santiago-Schwarz8 and colleagues described the generation of DC-like cells from the PBMNC of a single AML patient. In their studies, the terminal differentiation of an adherent DC-like population was achieved using a combination of GM-CSF, TNF-α, and IL-6. In the present study IL-6 failed to show any significant effect in generating DC-like cells from AML PBMNC or increasing allostimulatory ability of cultured AML-PBMNC (data not shown). Classically, DC are nonadherent cells. Moreover, in our experiments, cells with DC morphology, phenotype, and functional activity were obtained in the nonadherent fraction of the cultured AML PBMNC. The significance and reasons behind the observed differences in our results and those of Santiago-Schwarz are not clear. We speculate that differences in results may arise from differences in culture conditions and intrinsic variations in ability and default pathways of differentiation of leukemic cells obtained from various patients.
Our data are most compatible with derivation of the cultured dendritic cells from the malignant clone. In two forms of AML with very different cytogenetic and phenotypic characteristics, we show evidence for prominent representation of the malignant clone in the cultured cell populations. The Western blotting demonstration of CBFB-MYH11 in the culture from an inv(16) patient proves that AML cells continue to express the leukemic associated proteins even after undergoing cytokine-induced differentiation in vitro. The finding of trisomy 8 by FISH conclusively shows derivation of the DC from the malignant clone. These findings are consistent with those of Robinson et al,13 who found DC derived from the malignant clone in a single case of acute leukemia with a deletion of chromosome 5q.
It has been recently proposed that helper T cells contribute to the development of cytotoxic T cells by providing a priming signal to the APC, which then becomes fully competent to prime cognate cytotoxic T cells. The helper lymphocyte delivers the signal to the APC via the CD40-CD40L pathway. Stimulation of CD40 on the APC by anti-CD40 antibody or exogenous multimeric CD40 ligand can replace the requirement of helper T cells.14-16 The result of our study suggests that the addition of CD40L to GM-CSF and IL-4 may serve not only to facilitate generation of DC from AML myelomonocytic cells, but to activate the DC, enabling the generation of cytotoxic T cells with antileukemic reactivity.
The antileukemic cytotoxicity elicited from autologous lymphocytes after stimulation with leukemia-derived DC is similar to what we have previously observed for CML.7 Despite the heterogeneous nature of AML and the varied cytogenetic abnormalities of the patients tested in this study, the majority of the AML cells were able to generate DC and stimulate antileukemic cytotoxicity. Further study of these cells is warranted to determine the target antigens responsible for the observed immune activity. These results support the speculation that normal myeloid antigens expressed as aberrant forms or in aberrant levels maybe of greater utility in targeting immunotherapeutic approaches than a putative “leukemia-specific” epitope defined by a unique chromosomal abnormality associated with a particular form of leukemia.11
The potential therapeutic implications of this work are substantial. Leukemic DC can potentially be used as a cellular leukemia vaccine in vivo or to generate antileukemic T cells in vitro for adoptive immunotherapy. Their use in immunotherapy may eliminate minimal residual disease and convert transient responses into durable remissions in this normally fatal disease.
ACKNOWLEDGMENT
The authors thank Drs Mary Ellen Rybak (Schering-Plough) for providing IL-4 and Mario Sznol (CTEP-NCI) for TNF-α. We also thank Dr Margaret Kripke for useful discussions and suggestions.
Supported by funds from the Leukemia Society of America (Grant Ref No 6210-98), The National Institutes of Health (CA55164), and the Adler Foundation.
The publication costs of this article were defrayed in part by page charge payment. This article must therefore be hereby marked“advertisement” in accordance with 18 U.S.C. section 1734 solely to indicate this fact.
REFERENCES
Author notes
Address reprint requests to A. Choudhury, PhD, The University of Texas M.D. Anderson Cancer Center, Box 24, 1515 Holcombe Blvd, Houston, TX 77030.